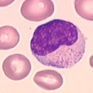
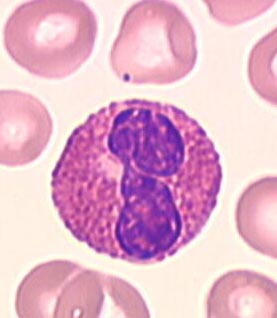

Immunologie - SIDA
|
Images des cellules immunitaires du sang
|

|
LYMPHOCYTE
La lignée lymphocytaire représente entre 24 et 40 % des leucocytes, de plus elle est polymorphe. En effet, elle comporte des cellules de toute taille dont le diamètre peut varier de 8 à 15 microns.Le rapport nucléoplasmique est élevé.Le cytoplasme est généralement bleu foncé et dépourvu de granulations.
 |
|
|
GRANULOCYTE
Les granulocytes sont caractérisés par des granulations intracytoplasmiques bien visibles et un noyau unique plurilobé. Leur taille varie de 12 à 18 microns; Ils représentent par leur nombre la première population leucocytairedu sang circulant et constituent entre 40 et 75 % des leucocytes.

|
|

|
MONOCYTES
Les monocytes sont les leucocytes les plus volumineux (20 à 25 microns de diamètre. Ils représentent 2 à 10 % des leucocytes.

|
|
Modifié le: vendredi 14 septembre 2018, 11:14